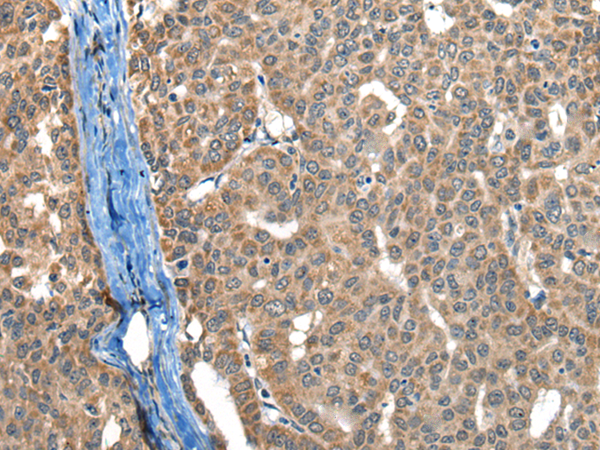

中文名稱:兔抗BOLA1多克隆抗體
|
Background: |
BOLA1 (BolA-like protein 1), also known as CGI-143, is a member of the BolA/yrbA family of proteins. Members of this family are homologs of the Escherichia coli protein, BolA. BolA-like proteins are evolutionarily conserved from prokaryotes to eukaryotes and are believed to play a role in cell-cycle regulation or cell proliferation possibly via some sort of transcription regulation of other genes. In addition, BolA-like proteins may contain nucleic-acid binding properties, as is suggested by a fold structure that is similar to the KH-fold, a motif known to participate in nucleic-acid binding. Characteristic of BolA-like proteins which typically consist of approximately 100 amino acids, BOLA1 is a 137 amino acid protein. |
|
Applications: |
ELISA, IHC |
|
Name of antibody: |
BOLA1 |
|
Immunogen: |
Full length fusion protein |
|
Full name: |
bolA family member 1 |
|
Synonyms: |
CGI-143 |
|
SwissProt: |
Q9Y3E2 |
|
ELISA Recommended dilution: |
5000-10000 |
|
IHC positive control: |
Human esophagus cancer and human liver cancer |
|
IHC Recommend dilution: |
40-200 |

購物車
幫助
021-54845833/15800441009
